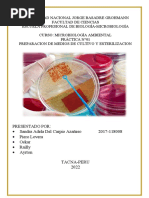

0% encontró este documento útil (0 votos)
91 vistas12 páginasReglamento y Prácticas de Microbiología
Este documento presenta el reglamento para ingresar al laboratorio de microbiología de la Facultad de Ingeniería Química de la Benemérita Universidad Autónoma de Puebla. Incluye 15 reglas sobre el uso apropiado del laboratorio, como la hora de entrada, uso de batas, limpieza, seguridad y etiquetado de muestras. También presenta el procedimiento para preparar medios de cultivo, incluyendo la suspensión de ingredientes, mezcla, ebullición, esterilización y pruebas funcionales
Cargado por
DaniDerechos de autor
© © All Rights Reserved
Nos tomamos en serio los derechos de los contenidos. Si sospechas que se trata de tu contenido, reclámalo aquí.
Formatos disponibles
Descarga como DOCX, PDF, TXT o lee en línea desde Scribd
0% encontró este documento útil (0 votos)
91 vistas12 páginasReglamento y Prácticas de Microbiología
Este documento presenta el reglamento para ingresar al laboratorio de microbiología de la Facultad de Ingeniería Química de la Benemérita Universidad Autónoma de Puebla. Incluye 15 reglas sobre el uso apropiado del laboratorio, como la hora de entrada, uso de batas, limpieza, seguridad y etiquetado de muestras. También presenta el procedimiento para preparar medios de cultivo, incluyendo la suspensión de ingredientes, mezcla, ebullición, esterilización y pruebas funcionales
Cargado por
DaniDerechos de autor
© © All Rights Reserved
Nos tomamos en serio los derechos de los contenidos. Si sospechas que se trata de tu contenido, reclámalo aquí.
Formatos disponibles
Descarga como DOCX, PDF, TXT o lee en línea desde Scribd